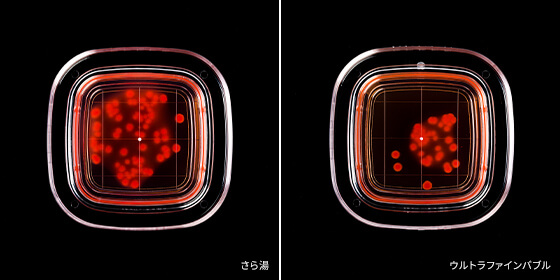

Feature 02
いつも通りにお湯を使うだけで、
水垢やピンク汚れを防ぎ、
家中の水まわりを綺麗で清潔に保つ
ウルトラファインバブルを含んだお湯を使用すると、水垢やピンク汚れ、ニオイやつまりの原因になる排水管の汚れが、さら湯と比べて洗い流されやすくなります。浴室やキッチン、洗面所など水まわりの日々の掃除負担が軽減されます。
ウルトラファインバブル給湯器で
あなたの毎日に驚きの輝きと、うるおいを。
ウルトラファインバブル給湯器なら、
非常に微細な泡を含んだお湯を家中に送り出すことができます。
目に見えないほどの小さな泡が水まわりの汚れを付きにくくし、
また、乾燥しがちな肌のうるおいを持続させます。
ウルトラファインバブル給湯器で毎日の暮らしをもっと豊かに。
「ウルトラファインバブル」は一般社団法人ファインバブル産業会の登録商標です。
直径1マイクロメートル未満の微細な泡で、細かい隙間にある汚れを落とす作用があり、その洗浄効果から幅広い分野で活用されています。
数十nmから1μm未満
ウイルスや煙と同等サイズ。微細運動をしながら、水中に長期残存(数週間から数ヶ月)。色は透明。
1μmから100μm未満
スギ花粉や黄砂と同等サイズ。直径約30μmの気泡で、非常にゆっくりと上昇。色は白濁。
100μm以上
髪の毛の直径と同等サイズ。上昇速度が速い(直径1mmの気泡で約5~6m/分)。泡そのものを目視できる。
「Air Bubble Technology(エアバブルテクノロジー)」は、微細な泡を水に溶け込ませる、Rinnai独自技術。長年の研究を重ねて開発された、このテクノロジーは、マイクロバブルバスユニットやウルトラファインバブル給湯器に使われています。毎日の入浴をよりリラックスできる時間に変え、家中の水まわりの掃除を楽に。Air Bubble Technologyで、暮らしに新しい体験を提供していきます。
「Air Bubble Technology(エアバブルテクノロジー)」は、微細な泡を水に溶け込ませる、Rinnai独自技術。長年の研究を重ねて開発された、このテクノロジーは、マイクロバブルバスユニットやウルトラファインバブル給湯器に使われています。毎日の入浴をよりリラックスできる時間に変え、家中の水まわりの掃除を楽に。Air Bubble Technologyで、暮らしに新しい体験を提供していきます。
Feature 01
ウルトラファインバブル給湯器を設置すれば、家中でウルトラファインバブル入りのお湯を使用することができます。リフォームの場合でも、大掛かりな工事の必要はありません。浴室や洗面所、キッチン、食洗機などお湯の配管がつながっている様々な場所へウルトラファインバブル入りのお湯を送ります。
Scene 01
ニオイやつまりの原因になる油汚れなどが流れやすくなり、排水口の汚れや、シンクの水垢を付きづらくします。
Scene 02
さら湯と比べて、ミネラル成分の付着を軽減して水垢を付きづらくし、排水口の汚れも軽減します。
Scene 03
汚れの原因菌が洗い流されやすくなり、浴室の床、浴槽の水垢、パッキンの汚れや排水口の汚れも付きづらくします。
Scene 01
ニオイやつまりの原因になる油汚れなどが流れやすくなり、排水口の汚れや、シンクの水垢を付きづらくします。
Scene 02
さら湯と比べて、ミネラル成分の付着を軽減して水垢を付きづらくし、排水口の汚れも軽減します。
Scene 03
汚れの原因菌が洗い流されやすくなり、浴室の床、浴槽の水垢、パッキンの汚れや排水口の汚れも付きづらくします。
Feature 02
ウルトラファインバブルを含んだお湯を使用すると、水垢やピンク汚れ、ニオイやつまりの原因になる排水管の汚れが、さら湯と比べて洗い流されやすくなります。浴室やキッチン、洗面所など水まわりの日々の掃除負担が軽減されます。
Feature 03
乾燥や、毛穴の開き、キメの乱れなど、お肌の悩みは尽きません。ウルトラファインバブル給湯器なら、汚れを落とすだけでなく、角層水分量を増加させ、入浴後や洗顔後の乾燥しやすい肌でもお肌のうるおいを持続させます。
ウルトラファインバブル入りのお湯を使用することで、汚れの原因菌を減少させたり、汚れが付きづらくなることが実験で確認されました。
Experiment 01
浴室の床や排水口など水まわりの汚れの原因菌は、あらゆる場所に存在します。ウルトラファインバブル給湯器なら、さら湯と比べて汚れの原因菌が洗い流されやすくなり、浴室の床やキッチンのシンクなどの汚れを軽減することが期待できます。
実験結果※
Experiment 02
キッチンの油はもちろん、洗面所の石鹸カスや化粧品のオイルは、気付かないうちに排水口の奥に溜まることでニオイやつまりの原因になってしまいます。ウルトラファインバブル給湯器なら、さら湯と比べて汚れが洗い流されやすくなり、排水管を清潔に保つことが期待できます。
実験結果※
Experiment 03
いつの間にかウロコ状の汚れとして出てくる、浴室の浴槽や鏡、キッチンのシンクの水垢。水道水に含まれるミネラル成分が結晶となり、浴槽やシンクなどにこびりついてしまいます。ウルトラファインバブル給湯器なら、さら湯と比べてミネラル成分の付着を軽減し、長年の使用でこびりつく水垢を抑制することが期待できます。
実験結果※
Experiment 04
「ピンク汚れ」など水まわりの汚れの原因菌は、浴室の床や排水口など様々な場所に存在します。ウルトラファインバブルのお湯が、「ピンク汚れ」の原因菌を洗い流しやすいことを確認しました。
実験結果※
※ 特定条件下における洗浄効果であり、実際の使用環境における実証結果ではありません。実際の洗浄効果は使用方法によって異なります。
乾燥しやすい入浴直後の肌に対して、汚れを落とすだけでなく角層水分量を増加させ肌のうるおいを持続させることを確認しました。
Experiment
入浴後の肌は乾燥しやすく、適切なケアが欠かせません。ウルトラファインバブルのお湯が、肌の角層水分量を持続させることを確認しました。
実験結果
さら湯と比べて化粧を落としやすくするクレンジング効果と、
髪の毛のツヤとコシを増加させる美髪効果を確認しました。
Experiment 01
ウルトラファインバブルのお湯で肌を洗浄することで、さら湯と比べて化粧品の付着量が30%減少。微細な泡を含んだお湯で洗うだけで化粧品の洗い残しを減らすことができ、毎日の肌管理をサポートします。
実験結果
Experiment 02
ウルトラファインバブルのお湯で髪を洗い流すことで、さら湯と比べて髪のツヤ感を表す毛髪光沢度が33%増加し、髪のコシの強さを表す毛髪引張り強度が38%増加することを確認しました。ウルトラファインバブルのお湯が、毎日の髪質管理をサポートします。
実験結果1
実験結果2
お客様の声
お湯の水圧を変化させて水中の空気を気泡化し、さらに気泡をせん断して細かくすることで微細の泡を発生させます。このウルトラファインバブルは、数週間から数ヶ月も水中に残る特性があります。
測定法:粒子軌跡解析法(PTA法)、測定水:純水※、水温 42℃、流量 12L/分、配管 10m、水圧:200kPa、環境条件:常温雰囲気、平均粒径:ガス給湯暖房用熱源機・ガスふろ給湯器用 100.3nm、ガス給湯器用119.0nm。
※この原水は、(一社)ファインバブル産業会(FBIA)の広告・表示ガイドラインで規定する超純水に相当します。
| 給湯能力 | 型式(品名コード) | 希望小売価格 |
|---|---|---|
| 24号(全自動) | RUFH-UE2408AW2-6(A)(26-7916) | ¥663,300(税込)¥603,000(税抜) |
| RUFH-UE2407AW2-3(A)(26-8327) | ¥591,800(税込)¥538,000(税抜) | |
| RVD-UE2405AW2-1(A)(26-8424)※ | ¥583,000(税込)¥530,000(税抜) |
| 給湯能力 | 型式(品名コード) | 希望小売価格 |
|---|---|---|
| 24号(全自動) | RUF-UE240EAW(24-7164) | ¥543,400(税込)¥494,000(税抜) |
| 20号(全自動) | RUF-UE200FAW(24-7180) | ¥514,800(税込)¥468,000(税抜) |
| 給湯能力 | 型式(品名コード) | 希望小売価格 |
|---|---|---|
| 24号 | RUX-UE2406W(A)(23-1636) | ¥271,700(税込)¥247,000(税抜) |
| 20号 | RUX-UE2016W(A)(23-1580) | ¥255,200(税込)¥232,000(税抜) |
| 給湯能力 | 型式(品名コード) | 希望小売価格 |
|---|---|---|
| 24号(全自動) | RUFH-UME2408AW2-6(26-6766) | ¥786,940(税込)¥715,400(税抜) |
| RUFH-UME2408AW2-1(26-6749) | ¥771,540(税込)¥701,400(税抜) |
| 給湯能力 | 型式(品名コード) | 希望小売価格 |
|---|---|---|
| 24号(全自動) | RUF-UME2406AW(A)(24-3796) | ¥661,540(税込)¥601,400(税抜) |
| 24号(自動) | RUF-UME2406SAW(A)(24-3800) | ¥604,340(税込)¥549,400(税抜) |
| 型式(品名コード) | 希望小売価格 |
|---|---|
| UF-MB1201AL-10A(B)(24-8046) | ¥19,800(税込)¥18,000(税抜) |
マイクロバブルバスユニット内蔵ふろ給湯器に、ウルトラファインバブル発生装置も搭載したモデルです。白濁のお湯で上質な入浴体験とリラクゼーションも求める方には、こちらがオススメです。浴室や洗面所、キッチンなどで水まわりの掃除負担が軽減されるだけではなく、浴槽では白濁のお湯でリラックス効果や肌へうるおいを与えることが期待されます。
Micro Bubble Bath Unitその他ラインアップ、型式の一覧は
デジタルカタログをご覧ください。
| 型式(品名コード) | 希望小売価格 |
|---|---|
| BC-332VC(A)-B(26-2133) | ¥44,000(税込)¥40,000(税抜) |
| BC-332VC(A)-W(26-2141) | ¥44,000(税込)¥40,000(税抜) |
| MC-332VC(A)-B(26-2125) | ¥42,900(税込)¥39,000(税抜) |
| MC-332VC(A)-W(26-2078) | ¥42,900(税込)¥39,000(税抜) |
(ガス給湯暖房用熱源機、ガスふろ給湯器用)
| 型式(品名コード) | 希望小売価格 |
|---|---|
| MBC-342VC(26-8717) | ¥70,400(税込)¥64,000(税抜) |
(ガス給湯器用)
| 型式(品名コード) | 希望小売価格 |
|---|---|
| BC-145V(A)(23-5176)※1 | ¥19,800(税込)¥18,000(税抜) |
| MC-145V(A)(23-5159)※2 | ¥19,800(税込)¥18,000(税抜) |
| 型式(品名コード) | 希望小売価格 |
|---|---|
| MBC-MB342VC(26-1544) | ¥73,700(税込)¥67,000(税抜) |
その他ラインアップ、型式の一覧は
デジタルカタログをご覧ください。
「ファインバブル」「ウルトラファインバブル」「FINE BUBBLE」「FBIA」ロゴは、一般社団法人ファインバブル産業会(FBIA)の登録商標です。リンナイ株式会社は一般社団法人ファインバブル産業会(FBIA)の会員です。ウルトラファインバブル給湯器は、排水管汚れの洗浄効果、浴室の洗浄効果、肌水分量の向上、肌汚れの洗浄効果にて、ファインバブル産業会( FBIA )の認証を取得しました。<ファインバブル技術利用製品/認証番号:CU7ab10031>
Catalog